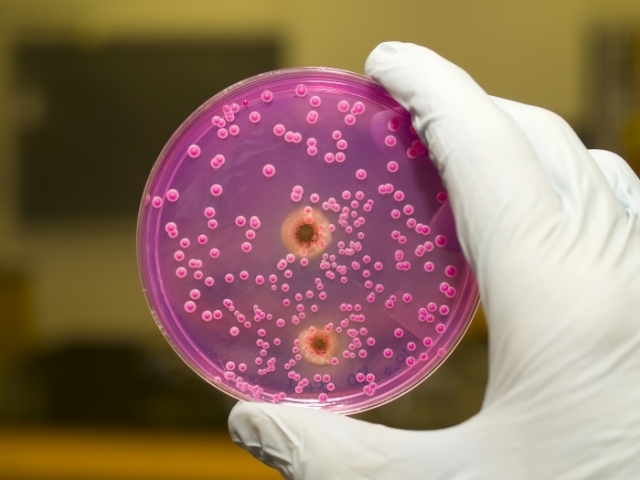
Чому від члена неприємний запах і що робити

Практично кожен представник сильної половини людства стикався з дуже неприємним явищем — неприємний запах від статевого члена.
І досить часто причина криється зовсім не в тому, що чоловік не дотримується правил та основ гігієни – їх може бути багато. Найчастіше – це наслідок низки захворювань, про що й поговоримо далі.

Правила особистої гігієни
Поява вельми специфічного запаху від геніталій може бути наслідком недотримання елементарних правил гігієни.
Так на тілі чоловіка є досить багато потових залоз і проток, які регулюють рівень теплообміну, допомагають не перегріватися при великих фізичних навантаженнях.
Крім поту з тіла, вологи, кожен день виділяється і смегма – спеціальна змазка, яка складається з секрету залоз і частинок епітелію. Вона виділяється і після накопичується в складках крайньої плоті – призначена для зволоження ніжною на пенісі шкірки, підтримання природного балансу і запобігання сухості.
Тим не менш, її рекомендовано під час щоденних водних процедур змивати, оскільки при її надлишку – створюється сприятливі умови для росту і розмноження патогенних мікроорганізмів.
Це відповідно провокує запалення, що супроводжується такими ознаками:
- Почервоніння головки члена і її інтенсивний свербіж.
- Дрібна висипка, плями по члену, які можуть утворювати виразки та глибокі рани.
- Відчуття болю при одяганні білизни, ходьбі.
Лікування неприємного запаху

Так неприємний запах від головки члена можна прибрати шляхом поєднання в курсі терапії антисептичних засобів та обмивання.
- Показано сидячі ванночки з додаванням відвару ромашки і череди, слабким розчином настоянки прополісу і марганцівки.
- Протріть член змоченим у Хлоргексидин ватним диском, головне – обирати 1% фортеці розчин.
- При утворенні виразок – обробка їх маззю Левомеколь.
Плюс до всього варто врахувати, що крім цього неприємний запах може вказувати на перебіг важкої хвороби – цукрового діабету, збої в роботі ендокринної системи.
Якщо охайність ваш девіз – варто пройти обстеження у лікаря.
Баланіт і неприємний запах

Серед широкого списку захворювань статевої сфери, досить часто дисбаланс мікрофлори може спровокувати і баланіт – запалення, що вражає на початку крайню плоть, після переходить на голівку, рідше вражає уретру і мочевыделительный канал.
Сприятливі умови для розвитку патології створюють такі фактори:
- Анатомія в будові крайньої плоті.
- Перебіг хронічної форми анемії і гормональний дисбаланс в організмі.
- Зниження імунітету і брак в організмі вітамінів.
У маленьких хлопчиків спровокувати його перебіг може фімоз – гострий запальний процес, що вражає крайню плоть і супроводжений гострими болями при сечовипусканні.
В запущеній формі на геніталіях з’являються тріщини, ерозії, у чоловіків знижується ерекція, болюче сечовипускання.
Лікування даного захворювання варто проводити антибіотиками за типом Еритроміцину або Бисептола, плюс обробляти шкіру речовинами та препаратами, що пригнічують патогенну мікрофлору:
- Примочки із слабкого розчину марганцівки або обробка Хлоргексидином – головне не робити розчин міцніше 0.05%, в іншому випадку це спровокує опік.
- Нанесіть на крайню плоть Левомеколью або ж прикладати тампони з 0.5% розчином Фенолу або ж Риванолу.
- З народних засобів — обробляйте геніталій водою, в яку додають нітрит срібла.
При діагностуванні хронічної форми патології – лікарі вдаються до обрізання крайньої плоті.
Кандидоз або молочниця
Також смердючий запах від статевого члена провокує і молочниця – турбує не просто кислуватий запах, але і виділення білого кольору.
Крім цього, спостерігаються такі симптоми, що вказують на протягом молочниці:
- Болюча в області геніталій набряклість, поява почервоніння головки пеніса.
- Різь і біль при відвідуванні туалету і сечовипусканні.
- Білястий наліт на члені, а при відсутності лікування – на його місці з’являються ерозії та ранки.
- Порушення ерекції і сім’явивергання.
Як позбутися молочниці:
- Насамперед, проводитися терапія протигрибковими складами – мазями для зовнішнього застосування і таблетками. Наприклад, це може бути крем Міконазол, Ифенек, Кандід розчин, таблетки Флуконазол або Ітраконазол.
- Дотримуватися правил особистої гігієни, тимчасово утримуючись від сексу.
Не варто займатися самолікуванням, навіть якщо ви точно впевнені, що у вас молочниця і вибраний вами препарат – допоможе. Діагноз, як і курс терапії повинен підбирати лікар, спираючись на результати огляду і аналізів.
Гарднерельоз

Коли смердить тухлою рибою статевий член – причини криються в ньому. Провокують його умовно-патогенні мікроорганізми, які в нормі присутні в кожному здоровому організмі, і ніяким чином не показує себе.
Але зниженні імунітету, інших небезпечних факторах – захворювання показує себе.
Крім рибного запаху, дане захворювання проявляється сверблячкою і проблемами з потенцією і сечовипусканням. Курс терапії передбачає наступне:
- На самому початку в сечовипускальний канал вводять розчин антисептиків, поєднуючи з антибактеріальною терапією.
- Призначають імуномодулятори та комплекс вітамінів.
- Відмовтеся від алкоголю, плюс виключити статеві контакти на період лікування.
Тут досить тижневого курсу терапії, хоча негативні симптоми йдуть на 2-3 добу лікування.
Група венеричних захворювань


Велика група захворювань, що викликають неприємний запах геніталій. Важливо пам’ятати, що при появі ряду симптомів варто негайно відвідати лікаря:
- неприємного запаху і дискомфорту при відвідуванні туалету, свербежу;
- набряклості геніталій і оточуючих шкірних покривів;
- виділень з пеніса і висипаннях на члені.
Чому з’являються симптоми – відповість тільки лікар, також як і на те, яке діагностовано ЗПСШ. Медикаментозні препарати і курс терапії повинен призначати лікар, оскільки при відсутності лікування можливі серйозні ускладнення, починаючи від запалення і закінчуючи поразкою внутрішніх органів.
Профілактичні заходи

Коли з позиції медицини немає приводу для хвилювання, тим не менш, від геніталій виходить неприємний душок – прийміть до уваги такі рекомендації і поради.
- Саме перший засіб – це щоденні водні процедури. Вода — теплою, мило – дитяче, або ж з нейтральним лужним рівнем.
- Не варто носити синтетичну білизну – вибирайте сімейні труси, зшиті з натуральних бавовняних тканин. Натуральні тканини добре вбирають вологу, пропускають повітря, не стискуючи при цьому руху. Труси міняють щодня.
- Використовуйте відвари лікарських трав, наприклад череда або ж ромашка.
Висновок
Головне пам’ятати, що практично існує чимало причин, захворювань, які провокують появу неприємного запаху статевого члена.
При появі неприємного амбре від геніталій, сопровожденного свербінням і палінням, набряком та появою висипань по тілу – не варто самому собі ставити діагноз і призначати ліки. Це прерогатива лікаря, який ставить діагноз і призначає курс терапії, спираючись на результати огляду і лабораторних аналізів.